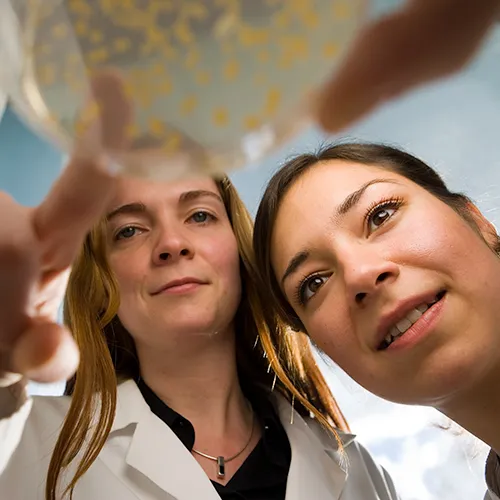
Students lab

School of Science
School of Science
Prof. Dr. Susanne Illenberger
Dean, Distinguished Lecturer of Biochemistry and Cell Biology
The School of Science provides an international and multidisciplinary environment for researchers in the natural sciences and mathematics. From numbers and quanta, molecules, and cells, to oceans and planets - cutting edge research in mathematics, physics and chemistry, the life- and geosciences advances our knowledge, addresses global problems, and creates new technology.
Below, you can find the overview of our research groups and the programs offered by the school.
If you would like to find out more about our faculty, including the professors with their research field, lecturers with their main field of teaching, and our adjunct staff, please visit this page.
For a Faculty list see the Faculty Directory